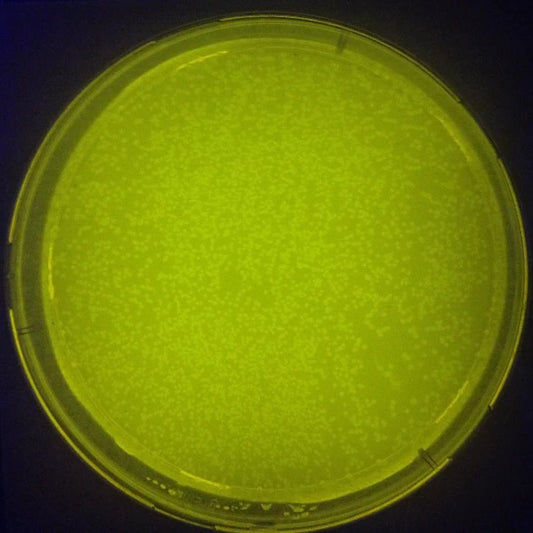
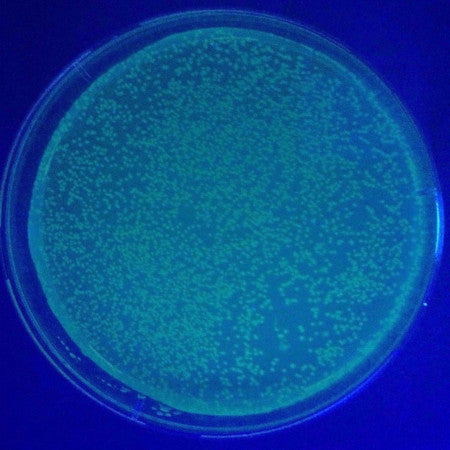

Collection: Products
-
2X TSS Bacterial Transformation Kit for Fast Preparation of Competent E.coli Cells
Regular price $ 110.00 USDRegular priceUnit price / perSale price $ 110.00 USD -
5-alpha Chemically Competent E. coli Cells for Cloning and Subcloning.
Regular price $ 120.00 USDRegular priceUnit price / perSale price $ 120.00 USD -
5-alpha Electrocompetent E. coli Cells | High Efficiency Transformation
Regular price $ 130.00 USDRegular priceUnit price / perSale price $ 130.00 USD -
Amine Functionalized Magnetic Nanoparticles | Proteins & Antibodies Purification
Regular price From $ 70.00 USDRegular priceUnit price / perSale price From $ 70.00 USD -
BirA Biotin Ligase, GST-tag
Regular price $ 400.00 USDRegular priceUnit price / perSale price $ 400.00 USD -
BirA Biotin Ligase, MBP-tag, Recombinant
Regular price $ 370.00 USDRegular priceUnit price / perSale price $ 370.00 USD -
BirA Biotin Protein Ligase, Recombinant
Regular price $ 240.00 USDRegular priceUnit price / perSale price $ 240.00 USD -
BL21 (λDE3) Chemically Competent E. coli Cells | Recombinant Proteins Production
Regular price $ 120.00 USDRegular priceUnit price / perSale price $ 120.00 USD -
BL21 (λDE3) Electrocompetent E. coli Cells | High Level Recombinant Protein
Regular price $ 130.00 USDRegular priceUnit price / perSale price $ 130.00 USD -
BL21(λDE3) pLPP – Lambda Protein Phosphatase Co-Expression System | Production of Unphosphorylated Proteins
Regular price $ 420.00 USDRegular priceUnit price / perSale price $ 420.00 USD -
BL21(λDE3) ΔserB Chemically Competent E.coli Cells for Phosphoserine Incorporation
Regular price $ 1,600.00 USDRegular priceUnit price / perSale price $ 1,600.00 USD -
BL21(λDE3) ΔserC Chemically Competent E.coli Cells for Protein Phosphorylation
Regular price $ 1,600.00 USDRegular priceUnit price / perSale price $ 1,600.00 USD -
BL21(λDE3) ΔserC ΔycdX Chemically Competent Cells for In Vivo Incorporation of Phosphothreonine
Regular price $ 2,600.00 USDRegular priceUnit price / perSale price $ 2,600.00 USD -
BL21(λDE3)pBirA Chemically Competent E.coli Cells for in vivo Biotinylation
Regular price $ 340.00 USDRegular priceUnit price / perSale price $ 340.00 USD -
C-His-pTrham Rapid Cloning and Gene Expression Kit
Regular price $ 550.00 USDRegular priceUnit price / perSale price $ 550.00 USD -
Carboxyl Functionalized Magnetic Nanoparticles
Regular price From $ 70.00 USDRegular priceUnit price / perSale price From $ 70.00 USD
Domestic Shipping in the US
Temperature sensitive products requiring shipping/handling on dry ice are shipped via UPS Next Day Air Saver. These products are delivered the next day if your order is placed before 3 PM PST. A dry ice surcharge is included in the shipping cost at checkout. For orders totaling over $1,000, free shipping and handling will be applied to the order.
International Shipping
Orders to be shipped internationally (outside of the US) can be shipped via DHL Express Worldwide or FedEx International Priority. Please contact info@amidbiosciences.com if you would like your company's shipping account to be used for the order. Our customers have sometimes negotiated lower shipping rates than us.
- Choosing a selection results in a full page refresh.
- Opens in a new window.